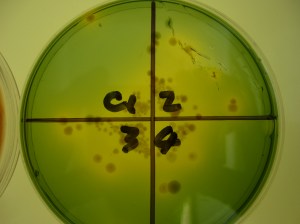
P1030885

We plan to update this section with more detail when we get time!
We are measuring oysters to estimate their growth rate. As with most aspects of the study, we measure randomly selected oysters in order to estimate growth across the batch.
After opening and carefully dissecting each oyster, we pulverse them to obtain a mushy fluid which we can test for bacteria and POMS virus.

Richard and Vicky at work opening oysters which are held in a marvellous Siminis oyster system device; Ika is coordinating this operation with the dissection team who are off to the left of this picture

After grinding up the oysters, their juices are stored in tubes at minus 80 degrees centigrade for later testing
We are testing the oysters using three methods:
1. Virology – quantitative polymerase chain reaction (qPCR) for OsHV-1 u-var in tissues
2. Microbiology – culture of the tissues on an agar surface to detect Vibrio bacteria
3. Microscopic examination – using thin sections of the whole oyster to check for parasites and other abnormalities